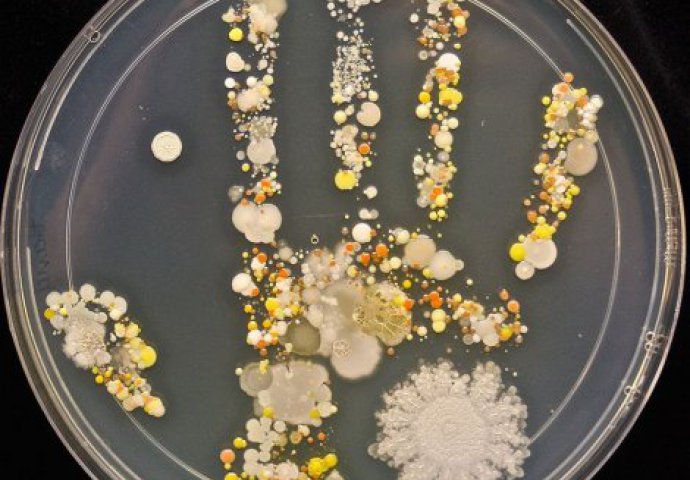

Ovi mikroorganizmi se nalaze na šakama vašeg djeteta nakon igranja napolju
Tasha Sturm, laboratorijska tehničarka iz Kalifornije, autorka je fotografija koje prikazuju kakvi sve mikroorganizmi žive na koži čovjeka
Tasha Sturm, laboratorijska tehničarka iz Kalifornije, autorka je fotografija koje prikazuju kakvi sve mikroorganizmi žive na koži čovjeka. Ona je proučavala otisak šake svog osmogodišnjeg sina, kako bi utvrdila šta se nalazi na njegovim dlanovima i prstima nakon igranja napolju.
Dječak je ostavio otisak u specijalnom gelu, pogodnom za uzgajanje mikrobioloških kultura. Uzorak je ostavljen da odstoji nekoliko dana, kako bi se bakterije razmnožavale.

Na fotografijama se vide mikroorganizmi sa zaštitnim membranama i bez njih. Oni stvaraju kolonije različitih boja, oblika i veličina.

Iako slike djeluju pomalo zastrašujuće, ali ne treba zaboraviti da su bakterije potpuno uobičajeni stanovnici naše kože.